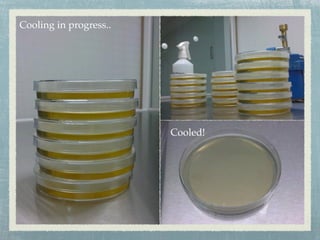
Cooling in progress..
Cooled!

Embed presentation
Download as KEY, PPTX







The document describes the first day of a life science program for secondary one students in 2010. It discusses preparing nutrient agar by autoclaving, pouring, and cooling the agar. It also mentions that on the first day students watched a video, did self introductions, and were introduced to using an autoclave to prepare the nutrient agar.